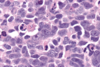

La lesión neuronal puede ser un proceso agudo, a menudo como consecuencia de la falta de … o de glucosa o de un traumatismo, o puede producirse a lo largo de años, como en los trastornos ….
La lesión neuronal puede ser un proceso agudo, a menudo como consecuencia de la falta de oxígeno o de glucosa o de un traumatismo, o puede producirse a lo largo de años, como en los trastornos degenerativos.
Las … … son evidentes a las 6- 12 h de una agresión hipóxica/isquémica irreversible.
«neuronas rojas»
Se refiere a los cambios observados después de hipoxia/isquemia aguda, hipoglucemia grave y otras agresiones agudas del SNC, que son los marcadores morfológicos iniciales de la muerte neuronal
lesión neuronal aguda («neuronas rojas»)
Se refiere a la muerte celular como consecuencia de una enfermedad progresiva de meses a años de duración, como la esclerosis lateral amiotrófica y la enfermedad de Alzheimer.
lesión neuronal subaguda y crónica («degeneración»)
Es la degeneración axónica después de la interrupción de las fibras nerviosas
degeneración walleriana
Es el marcador histopatológico más importante de lesión del SNC con independencia de la causa y se caracteriza por hipertrofia e hiperplasia de los astrocitos.
Gliosis

Figura 28. 1 Astrocitos reactivos. La tinción inmunohistoquímica para la proteína gliofibrilar ácida (morrón) pone de relieve las prolongaciones astrocíticas estrelladas que dan nombre a estas células.
Son células fagocíticas derivadas en las primeras fases del desarrollo embrionario del saco vitelino o del hígado fetal que actúan como macrófagos residentes del SNC
Microglia
La lesión neuronal provoca con frecuencia muerte celular, por apoptosis o ….
necrosis
es dificil detectar la pérdida de sinapsis o de neuronas,
Causado por un incremento de la salida de líquido de los vasos sanguíneos y por la lesión de distintas células del SNC
Edema cerebral (con más precisión, el edema del parénquima cerebral)
Es un aumento del líquido extracelular por alteración de la barrera hematoencefálica y aumento de la permeabilidad vascular, que permite la salida de líquido del compartimento intravascular a los espacios intercelulares cerebrales.
Edema vasógeno
Es un aumento del líquido intracelular secundario a una lesión de la membrana celular neuronal, glial o endotelial, como se produce por una agresión hipóxica/isquémica generalizada o una alteración metabólica que impide mantener los gradientes iónicos de membrana normales.
Edema citotóxico
Es la acumulación excesiva de LCR en el sistema ventricular
Hidrocefalia
La mayoría de los casos de hidrocefalia están causados por alteración del flujo y de la reabsorción de LCR; la producción excesiva es una causa infrecuente asociada a los tumores del plexo coroideo.

Figura 28.2 Hidrocefalia. Ventrículos laterales dilatados observados en corte frontal a través de la región centraI del tálamo.
Si la hidrocefalia se produce en un niño antes del cierre de las suturas craneales, la cabeza aumenta de tamaño. Por el contrario, después del cierre de las suturas, la hidrocefalia produce expansión de los ventrículos y aumento de la …… intracraneal, sin cambios en el perímetro cefálico
presión
Es un desplazamiento de tejido cerebral más allá de los pliegues durales rígidos (la hoz y la tienda) o a través de aberturas en el cráneo por hipertensión intracraneal.
Hernia
El aumento de volumen cerebral desplaza el …. y provoca hipertensión intracraneal;
LCR
Se produce cuando una expansión unilateral o asimétrica de un hemisferio cerebral desplaza la circunvolución del cíngulo por debajo de la hoz. Esto puede causar compresión de la arteria cerebral anterior y de sus ramas con infartos secundarios.
hernia subfalcina (cingulada)
Se produce cuando la cara medial del lóbulo temporal se comprime contra el borde libre de la tienda. El desplazamiento progresivo del lóbulo temporal comprime el tercer par craneal y causa midriasis y alteración de los movimientos oculares en el lado de la lesión.
hernia transtentorial (uncal, temporal mesial)
Es el desplazamiento de las amígdalas cerebelosas a través del agujero occipital. Este tipo de hernia es potencialmente mortal, porque comprime el tronco encefálico y afecta a centros bulbares respiratorios y cardíacos vitales.
Hernia amigdalina

Principales síndromes con hernias cerebrales: subfalcina, transtentorial y amigdalina.
El edema cerebral es la acumulación excesiva de líquido en el … cerebral. La hidrocefalia es un aumento de volumen del LCR en todo o en parte del sistema ….
parénquima
ventricular
El aumento de la presión intracraneal puede provocar … cerebral, descenso de perfusión e … secundario de las zonas afectadas.
hernia
infarto
Es una malformación del extremo anterior del tubo neural que provoca ausencia de la mayor parte del encéfalo y de la bóveda craneal.
Anencefalia